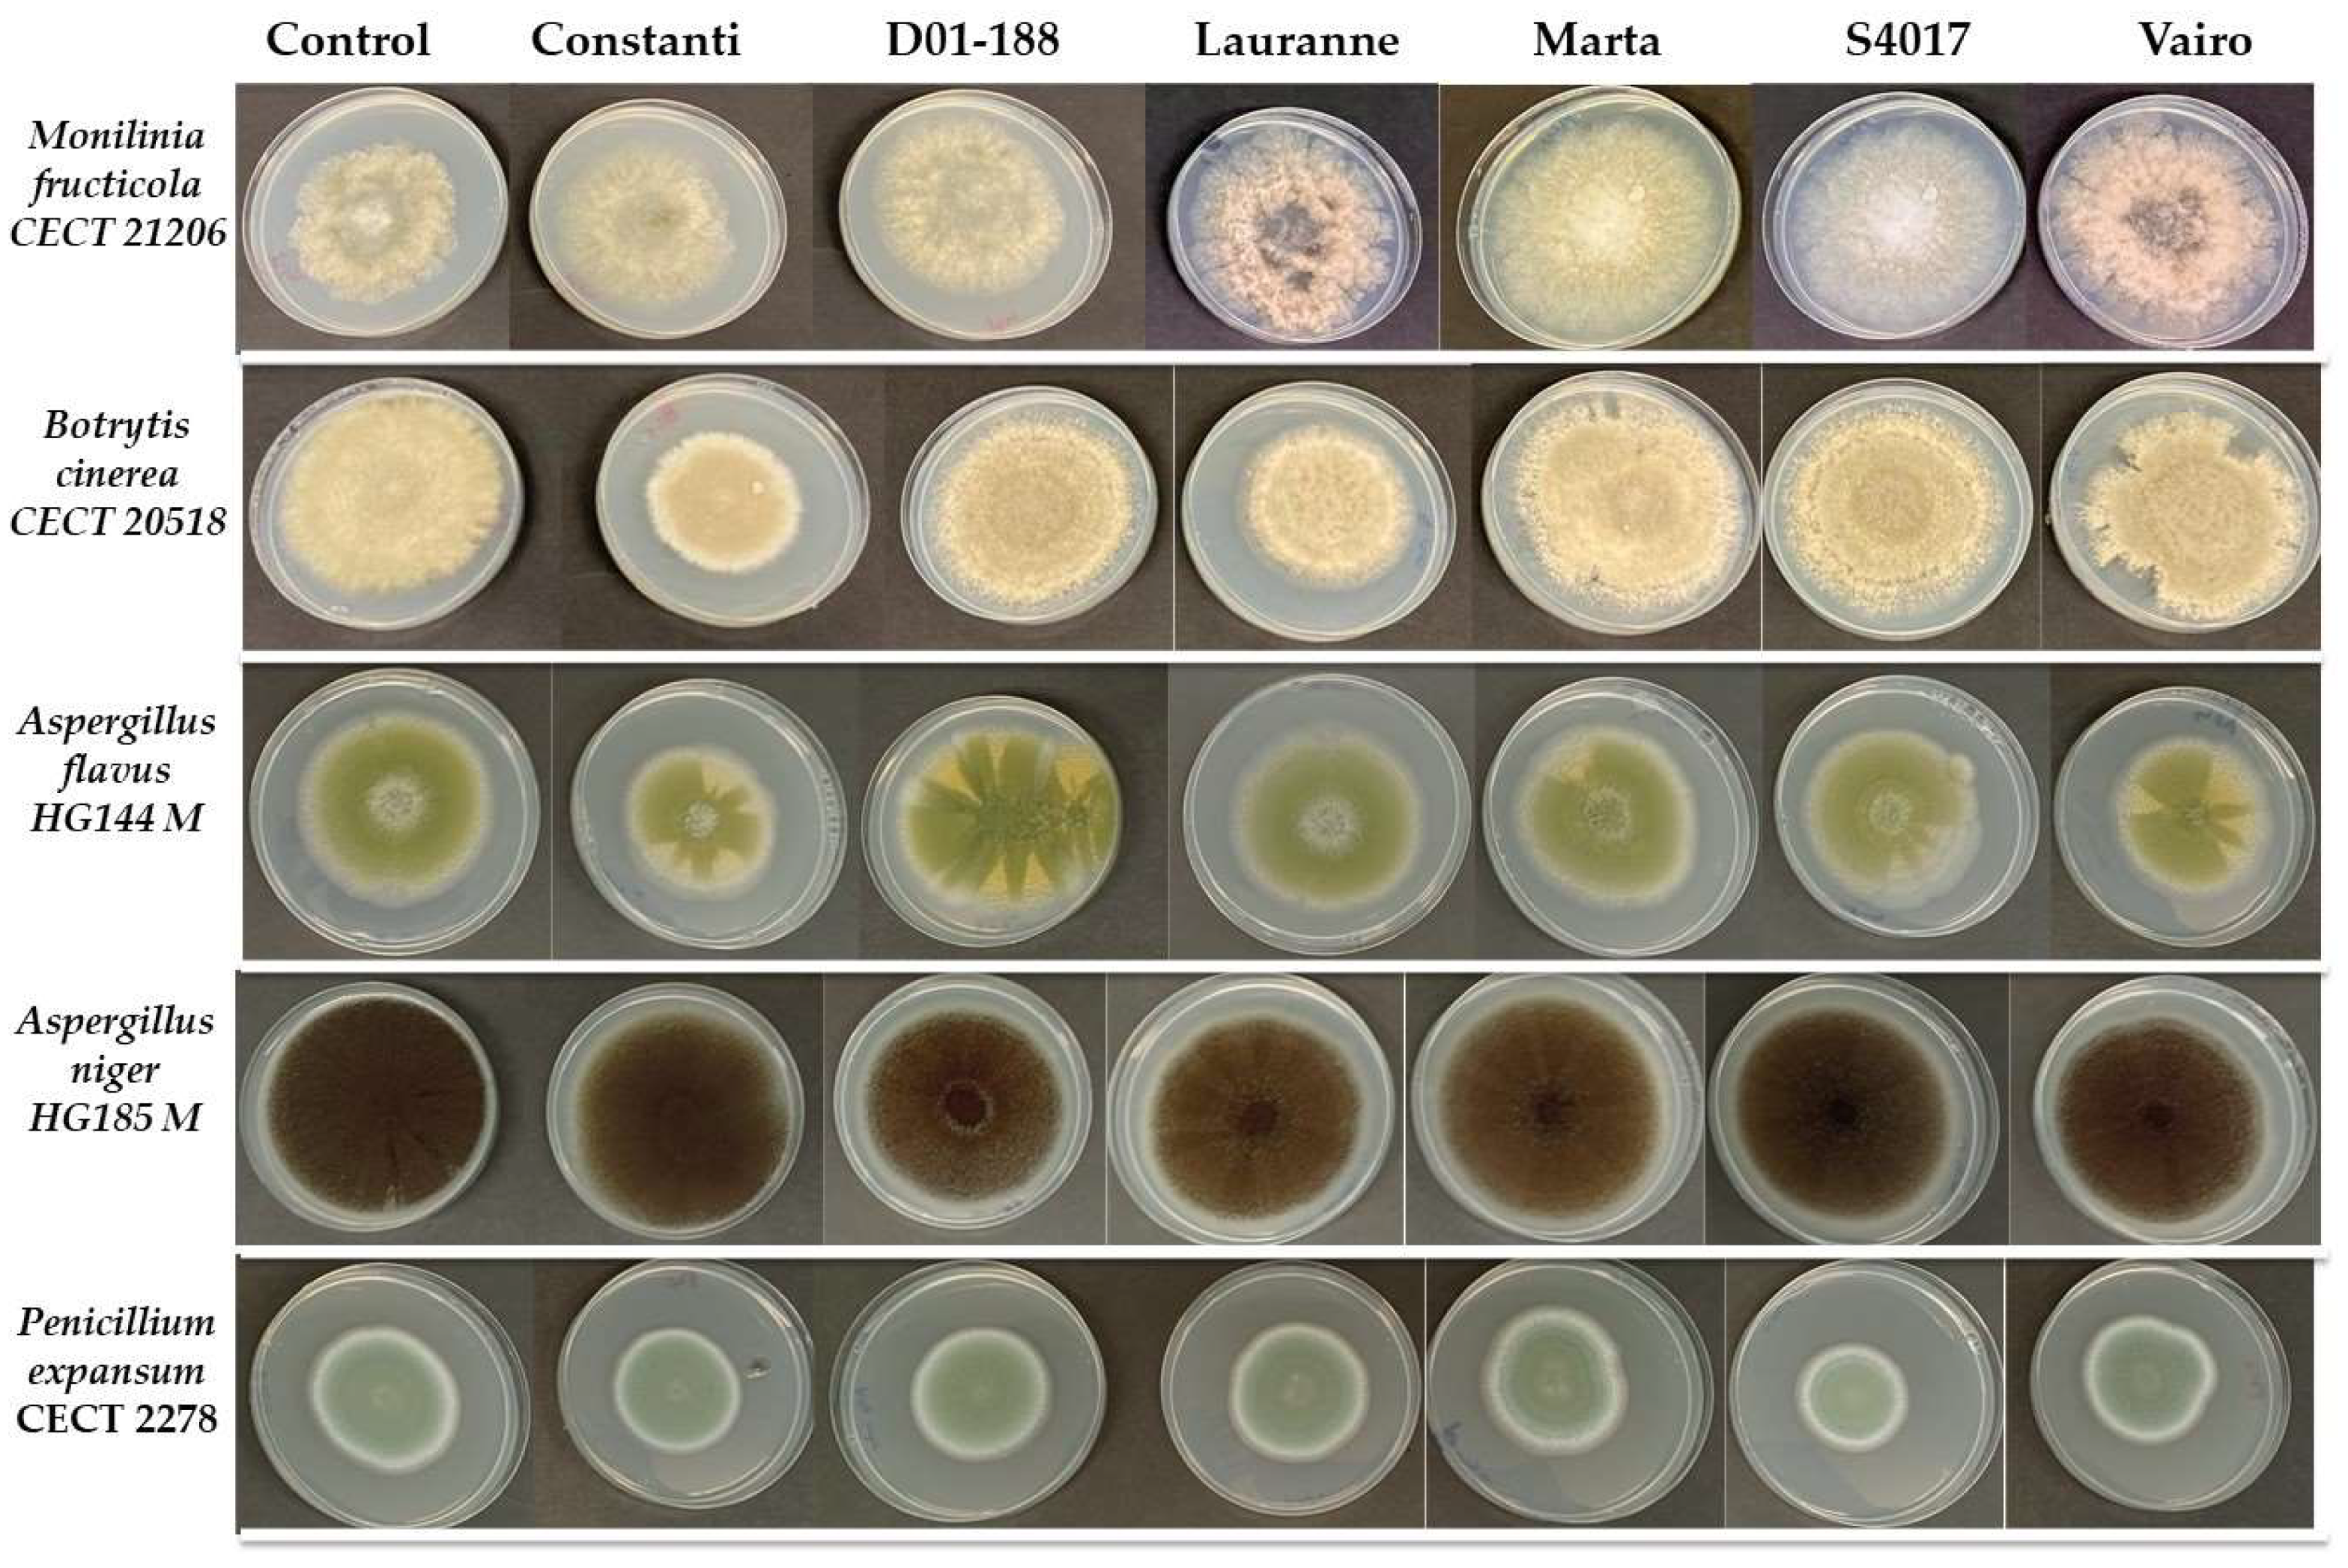
Molecules 30 02614 g001

Antioxidant and Antimicrobial Activities of Optimized Extract Obtained from Almond Shell Residues
Abstract
1. Introduction
2. Results
2.1. Phenolic Compounds and Flavonoids of Extracts Obtained from the Shells of Different Almond Varieties
2.2. Antioxidant Activity of Extracts Obtained from the Shells of Different Almond Varieties
2.3. Antimicrobial Activity of Extracts Obtained from the Shells of Different Almond Varieties
2.4. Multivariate Analysis of the Parameters Studied
3. Discussion
4. Materials and Methods
4.1. Plant Material
4.2. Bacterial and Fungal Strains
4.3. Extraction of Total Phenolic Compounds and Flavonoids
4.4. Determination of Total Phenolic Compounds and Flavonoids Content
4.5. Separation and Identification of Bioactive Compounds
4.6. Antioxidant Determination of the Phenolic Extracts
4.7. Antimicrobial Activity Determination
4.8. Statistical Analysis
5. Conclusions
Author Contributions
Funding
Institutional Review Board Statement
Informed Consent Statement
Data Availability Statement
Conflicts of Interest
References
- Llompart, M.; Barceló, M.; Pou, J.; Luna, J.M.; Miarnau, X.; Garau, M.C. Adaptation of almond cultivars in majorca island: Agronomical, productive, and fruit quality characteristics. Agronomy 2024, 14, 1927. [Google Scholar] [CrossRef]
- Sottile, F.; Massaglia, S.; Peano, C. Ecological and economic indicators for the evaluation of almond (Prunus dulcis L.) orchard renewal in Sicily. Agriculture 2020, 10, 301. [Google Scholar] [CrossRef]
- D’Agostino, G.; Merra, R.; Sottile, F.; Lazzara, G.; Bruno, M. Almonds By-Product Microcrystalline Cellulose as Stucco for Wooden Artifacts. Sustainability 2023, 15, 7800. [Google Scholar] [CrossRef]
- Botta, L.; Titone, V.; Mistretta, M.C.; La Mantia, F.P.; Modica, A.; Bruno, M.; Sottile, F.; Lopresti, F. PBAT based composites reinforced with microcrystalline cellulose obtained from softwood almond shells. Polymers 2021, 13, 2643. [Google Scholar] [CrossRef]
- Barral-Martinez, M.; Fraga-Corral, M.; Garcia-Perez, P.; Simal-Gandara, J.; Prieto, M.A. Almond by-products: Valorization for sustainability and competitiveness of the industry. Foods 2021, 10, 1793. [Google Scholar] [CrossRef]
- Ahmed, M.F.; Popovich, D.G.; Whitby, C.P.; Rashidinejad, A. Phenolic compounds from macadamia husk: An updated focused review of extraction methodologies and antioxidant activities. Food Bioprod. Process. 2024, 148, 165–175. [Google Scholar] [CrossRef]
- Casquete, R.; Benito, M.J.; Martín, A.; Martínez, A.; Rivas, M.A.; Córdoba, M.G. Influence of different extraction methods on the compound profiles and functional properties of extracts from solid by-products of the wine industry. LWT 2022, 170, 114097. [Google Scholar] [CrossRef]
- Gudiño, I.; Martín, A.; Casquete, R.; Prieto, M.H.; Ayuso, M.C.; Córdoba, M.D.G. Evaluation of broccoli (Brassica oleracea var. italica) crop by-products as sources of bioactive compounds. Sci. Hortic. 2022, 304, 111284. [Google Scholar] [CrossRef]
- Badalamenti, N.; Bruno, M.; Loizzo, M.R.; Puccio, V.; Gaglio, R.; Francesca, N.; Settanni, L.; Sottile, F. Antibacterial activity and chemical characterization of almond (Prunus dulcis L.) peel extract. Nat. Prod. Res. 2023, 37, 1680–1686. [Google Scholar] [CrossRef]
- Bisignano, C.; Filocamo, A.; La Camera, E.; Zummo, S.; Fera, M.T.; Mandalari, G. Antibacterial activities of almond skins on cagA-positive and-negative clinical isolates of Helicobacter pylori. BMC Microbiol. 2013, 13, 103. [Google Scholar] [CrossRef]
- Simonetti, G.; Brasili, E.; Pasqua, G. Antifungal Activity of Phenolic and Polyphenolic Compounds from Different Matrices of Vitis vinifera L. against Human Pathogens. Molecules 2020, 25, 3748. [Google Scholar] [CrossRef] [PubMed]
- Monagas, M.; Garrido, I.; Lebrón-Aguilar, R.; Bartolome, B.; Gómez-Cordovés, C. Almond (Prunus dulcis (Mill.) DA Webb) skins as a potential source of bioactive polyphenols. J. Agric. Food Chem. 2007, 55, 8498–8507. [Google Scholar] [CrossRef] [PubMed]
- Arráez-Román, D.; Fu, S.; Sawalha, S.M.; Segura-Carretero, A.; Fernández-Gutiérrez, A. HPLC/CE-ESI-TOF-MS methods for the characterization of polyphenols in almond-skin extracts. Electrophoresis 2010, 31, 2289–2296. [Google Scholar] [CrossRef] [PubMed]
- De la Rosa, L.A.; Álvarez-Parrilla, E.; García-Fajardo, J.A. Identificación de compuestos fenólicos en extractos de almendra (Prunus dulcis) y nuez pecana (Carya illinoinensis) mediante cromatografía líquida acoplada a espectrometría de masas en tándem (HPLC-MS/MS). TIP Rev. Espec. Cienc. Quím.-Biol. 2019, 22, 1–13. [Google Scholar] [CrossRef]
- Gong, Y.; Pegg, R.B.; Carr, E.C.; Parrish, D.R.; Kellett, M.E.; Kerrihard, A.L. Chemical and nutritive characteristics of tree nut oils available in the US market. Eur. J. Lipid Sci. Technol. 2017, 119, 1600520. [Google Scholar] [CrossRef]
- Xu, M.; Liu, P.; Jia, X.; Zhai, M.; Zhou, S.; Wu, B.; Guo, Z. Metabolic profiling revealed the organ-specific distribution differences of tannins and flavonols in pecan. Food Sci. Nutr. 2020, 8, 4987–5006. [Google Scholar] [CrossRef]
- Moreno Gracia, B.; Laya Reig, D.; Rubio-Cabetas, M.J.; Sanz García, M.A. Study of phenolic compounds and antioxidant capacity of spanish almonds. Foods 2021, 10, 2334. [Google Scholar] [CrossRef]
- Queirós, C.S.; Cardoso, S.; Lourenço, A.; Ferreira, J.; Miranda, I.; Lourenço, M.J.V.; Pereira, H. Characterization of walnut, almond, and pine nut shells regarding chemical composition and extract composition. Biomass Convers. Biorefin. 2020, 10, 175–188. [Google Scholar] [CrossRef]
- Esfahlan, A.J.; Jamei, R.; Esfahlan, R.J. The importance of almond (Prunus amygdalus L.) and its by-products. Food Chem. 2010, 120, 349–360. [Google Scholar] [CrossRef]
- Barreira, J.C.; Ferreira, I.C.; Oliveira, M.B.P.; Pereira, J.A. Antioxidant activities of the extracts from chestnut flower, leaf, skins and fruit. Food Chem. 2008, 107, 1106–1113. [Google Scholar] [CrossRef]
- Hong, S.; Joo, T.; Jhoo, J.W. Antioxidant and anti-inflammatory activities of 3,5-dicaffeoylquinic acid isolated from Ligularia fischeri leaves. Food Sci. Biotechnol. 2015, 24, 257–263. [Google Scholar] [CrossRef]
- Smeriglio, A.; Mandalari, G.; Bisignano, C.; Filocamo, A.; Barreca, D.; Bellocco, E.; Trombetta, D. Polyphenolic content and biological properties of Avola almond (Prunus dulcis Mill. D.A. Webb) skin and its industrial byproducts. Ind. Crops Prod. 2016, 83, 283–293. [Google Scholar] [CrossRef]
- Hyun, J.; Woo, Y.; Hwang, D.S.; Jo, G.; Eom, S.; Lee, Y.; Park, J.C.; Lim, Y. Relationships between structures of hydroxyflavones and their antioxidative effects. Bioorg. Med. Chem. Lett. 2010, 20, 5510–5513. [Google Scholar] [CrossRef] [PubMed]
- Yu, J.; Ahmedna, M.; Goktepe, I.; Dai, J. Peanut skin procyanidins: Composition and antioxidant activities as affected by processing. J. Food Compos. Anal. 2006, 19, 364–371. [Google Scholar] [CrossRef]
- Rojas-González, A.; Figueroa-Hernández, C.Y.; González-Rios, O.; Suárez-Quiroz, M.L.; González-Amaro, R.M.; Hernández-Estrada, Z.J.; Rayas-Duarte, P. Coffee chlorogenic acids incorporation for bioactivity enhancement of foods: A review. Molecules 2022, 27, 3400. [Google Scholar] [CrossRef]
- Kashyap, D.; Tuli, H.S.; Sharma, A.K. Ursolic acid (UA): A metabolite with promising therapeutic potential. Life Sci. 2016, 146, 201–213. [Google Scholar] [CrossRef]
- Sheikh, I.; Sharma, V.; Tuli, H.S.; Aggarwal, D.; Sankhyan, A.; Vyas, P.; Bishayee, A. Cancer chemoprevention by flavonoids, dietary polyphenols and terpenoids. Biointerface Res. Appl. Chem. 2020, 11, 8502–8537. [Google Scholar] [CrossRef]
- Negro, C.; Tommasi, L.; Miceli, A. Phenolic compounds and antioxidant activity from red grape marc extracts. Bioresour. Technol. 2003, 87, 41–44. [Google Scholar] [CrossRef]
- Martins, N.; Barros, L.; Ferreira, I.C. In vivo antioxidant activity of phenolic compounds: Facts and gaps. Trends Food Sci. Technol. 2016, 48, 1–12. [Google Scholar] [CrossRef]
- Fernandez-Panchon, M.S.; Villano, D.; Troncoso, A.M.; Garcia-Parrilla, M.C. Antioxidant activity of phenolic compounds: From in vitro results to in vivo evidence. Crit. Rev. Food Sci. Nutr. 2008, 48, 649–671. [Google Scholar] [CrossRef]
- Eseberri, I.; Trepiana, J.; Léniz, A.; Gómez-García, I.; Carr-Ugarte, H.; González, M.; Portillo, M.P. Variability in the beneficial effects of phenolic compounds: A review. Nutrients 2022, 14, 1925. [Google Scholar] [CrossRef] [PubMed]
- Cheynier, V. Phenolic compounds: From plants to foods. Phytochem. Rev. 2012, 11, 153–177. [Google Scholar] [CrossRef]
- Musarra-Pizzo, M.; Ginestra, G.; Smeriglio, A.; Pennisi, R.; Sciortino, M.T.; Mandalari, G. The antimicrobial and antiviral activity of polyphenols from almond (Prunus dulcis L.) skin. Nutrients 2019, 11, 2355. [Google Scholar] [CrossRef] [PubMed]
- Mandalari, G.; Bisignano, C.; D’Arrigo, M.; Ginestra, G.; Arena, A.; Tomaino, A.; Wickham, M.S.J. Antimicrobial potential of polyphenols extracted from almond skins. Lett. Appl. Microbiol. 2010, 51, 83–89. [Google Scholar] [CrossRef]
- Bouaziz, F.; Koubaa, M.; Chaabene, M.; Barba, F.J.; Ghorbel, R.E.; Chaabouni, S.E. High throughput screening for bioactive volatile compounds and polyphenols from almond (Prunus amygdalus) gum: Assessment of their antioxidant and antibacterial activities. J. Food Process. Preserv. 2017, 41, e12996. [Google Scholar] [CrossRef]
- Kurek, A.N.N.A.; Grudniak, A.M.; Kraczkiewicz-Dowjat, A.; Wolska, K.I. New antibacterial therapeutics and strategies. Pol. J. Microbiol. 2011, 60, 3. [Google Scholar] [CrossRef]
- Zhao, Y.; Chen, M.; Zhao, Z.; Yu, S. The antibiotic activity and mechanisms of sugarcane (Saccharum officinarum L.) bagasse extract against food-borne pathogens. Food Chem. 2015, 185, 112–118. [Google Scholar] [CrossRef]
- Lou, Z.; Wang, H.; Zhu, S.; Ma, C.; Wang, Z. Antibacterial activity and mechanism of action of chlorogenic acid. J. Food Sci. 2011, 76, M398–M403. [Google Scholar] [CrossRef]
- Wang, C.M.; Hsu, Y.M.; Jhan, Y.L.; Tsai, S.J.; Lin, S.X.; Su, C.H.; Chou, C.H. Structure Elucidation of Procyanidins Isolated from Rhododendron formosanum and Their Anti-Oxidative and Anti-Bacterial Activities. Molecules 2015, 20, 12787–12803. [Google Scholar] [CrossRef]
- Mendoza, L.; Yañez, K.; Vivanco, M.; Melo, R.; Cotoras, M. Characterization of extracts from winery by-products with antifungal activity against Botrytis cinerea. Ind. Crops Prod. 2013, 43, 360–364. [Google Scholar] [CrossRef]
- Hajji-Hedfi, L.; Rhouma, A.; Al-Judaibi, A.A.; Hajlaoui, H.; Hajlaoui, F.; Azeem, A.M.A. Valorization of Capsicum annuum seed extract as an antifungal against Botrytis cinerea. Waste Biomass Valorization 2024, 15, 2559–2573. [Google Scholar] [CrossRef]
- Rodrigues, M.H.P.; Marques, C.G.; de Almeida Senna, C.; Cerqueira, M.B.R.; Kupski, L.; Furlong, E.B. Patulin in tomatoes and the inhibitory capacity of their phenolic extracts against Penicillium expansum. Food Res. Int. 2022, 162, 112085. [Google Scholar] [CrossRef] [PubMed]
- Jahani, M.; Pira, M.; Aminifard, M.H. Antifungal effects of essential oils against Aspergillus niger in vitro and in vivo on pomegranate (Punica granatum) fruits. Sci. Hortic. 2020, 264, 109188. [Google Scholar] [CrossRef]
- Liu, Y.; Benohoud, M.; Yamdeu, J.H.G.; Gong, Y.Y.; Orfila, C. Green extraction of polyphenols from citrus peel by-products and their antifungal activity against Aspergillus flavus. Food Chem. 2021, 12, 100144. [Google Scholar] [CrossRef]
- Shraim, A.M.; Ahmed, T.A.; Rahman, M.M.; Hijji, Y.M. Determination of total flavonoid content by aluminum chloride assay: A critical evaluation. LWT 2021, 150, 111932. [Google Scholar] [CrossRef]
- Kondo, S.; Tsuda, K.; Muto, N.; Ueda, J.E. Antioxidative activity of apple skin or flesh extracts associated with fruit development on selected apple cultivars. Sci. Hortic. 2002, 96, 177–185. [Google Scholar] [CrossRef]
- Cano, A.; Arnao, M.B. Hydrophilic and lipophilic antioxidant activity in different leaves of three lettuce varieties. Int. J. Food Prop. 2005, 8, 521–528. [Google Scholar] [CrossRef]

| Total Phenols | Flavonoids | |||||
|---|---|---|---|---|---|---|
| Extract | Mean | TD * | Mean | TD | ||
| Constanti | 6883.35 | ± | 496.76 ab | 3405.80 | ± | 569.93 a |
| D01-188 | 5375.22 | ± | 454.32 b | 3520.04 | ± | 55.82 a |
| Lauranne | 7318.20 | ± | 150.11 a | 2099.35 | ± | 9.20 b |
| Marta | 6168.95 | ± | 322.20 b | 1344.62 | ± | 194.37 c |
| S4017 | 3332.28 | ± | 166.49 c | 3350.67 | ± | 29.93 a |
| Vairo | 3852.87 | ± | 522.05 c | 3036.43 | ± | 9.36 a |
| Peak | Rt (min) | [M − H]− | HPLC-ESI(-)-MSn Experiment m/z | Compounds Identified | Constanti | D01-188 | Lauranne | Marta | S4017 | Vairo |
|---|---|---|---|---|---|---|---|---|---|---|
| Phenolic Compounds | ||||||||||
| 1 | 3.18 | 581 | 393; 525; 582; 637 | Hydroxycinnamic acid 1 | 25.6 b | 19.3 b | 28.64 b | 164.22 a | 22.69 b | 19.97 b |
| 2 | 13.03 | 163 | 135; 145; 377 | Trans-p-coumaric acid 2 | 102.23 a | 25.3 b | 92.49 a | 8.26 b | 7.31 b | 6.99 b |
| 3 | 16.39 | 137 | 377 | p-Hydroxy-benzoic acid 3 | 87.31 a | 57.20 a | 0.00 b | 0.00 b | 0.00 b | 0.00 b |
| 4 | 17.08 | 163 | 164; 271 | p-Coumaric acid 2 | 162.13 a | 0.00 b | 0.00 b | 0.00 b | 0.00 b | 0.00 b |
| 5 | 21.32 | 515 | - | 4,5-Dicaffeoylquinic acid 1 | 0.00 b | 220.02 a | 0.00 b | 0.00 b | 320.35 a | 290.10 a |
| 6 | 24.04 | 303 | 116; 250; 176 | Dihydeoquercetin 2 | 56.12 b | 48.14 b | 60.48 b | 202.47 a | 39.88 b | 49.75 b |
| 7 | 26.05 | 149 | 121 | 3,6,2′,3′-Tetrahydroxyflavone 1 | 132.98 a | 70.16 b | 172.82 a | 183.46 a | 65.27 b | 63.09 b |
| 8 | 26.17 | 479 | 480 | Myricetin glucoside 4 | 0.00 c | 0.00 c | 34.07 a | 15.55 b | 0.00 c | 0.00 c |
| 9 | 13.96 | 475 | 182; 209; 210; 476 | Dimethyl ellagic acid pentoside 5 | 0.00 c | 0.00 c | 27.36 a | 11.38 b | 0.00 c | 0.00 c |
| 10 | 20.20 | 577 | 149; 193 | Procyanidin dimer B [Epi]catechin dimer 6 | 45.32 b | 54.14 b | 99.22 a | 367.8 b | 23.69 b | 24.82 b |
| Acids | ||||||||||
| 11 | 2.76 | 131 | 104 | 2-Methylsuccinic acid 1 | 0.00 c | 0.00 c | 0.00 c | 0.00 c | 232.60 a | 49.93 b |
| 12 | 2.92 | 195 | 103; 129; 357 | Gluconic acid 1 | 156.31 a | 80.48 b | 0.00 c | 0.00 c | 57.89 b | 0.00 c |
| 13 | 3.02 | 191 | 109; 192 | Quinic acid 1 | 261.79 a | 190.82 b | 0.00 e | 0.00 e | 107.79 c | 57.45 d |
| 14 | 3.07 | 100 | 112; 128; 154; 214 | 4-(Pentanamidomethyl) benzoic acid 1 | 0.00 c | 0.00 c | 198.68 a | 142.07 b | 0.00 c | 0.00 c |
| 15 | 3.20 | 133 | 115; 175 | Malic acid 1 | 38.30 b | 228.69 a | 0.00 c | 0.00 c | 65.75 b | 197.41 a |
| 16 | 18.05 | 487 | 488; 489 | Pygenic acid C 1 | 11.27 b | 0.00 c | 0.00 c | 0.00 c | 14.68 b | 261.39 a |
| 17 | 18.64 | 119 | 141; 437; 453 | 2,4,6-Trimethylbenzoic acid 1 | 0.00 c | 0.00 c | 201.76 b | 253.73 a | 0.00 c | 0.00 c |
| Others | ||||||||||
| 18 | 15.85 | 300 | 132; 301; 344 | N-Acetyl-alpha-D-glucosamine 1-phosphate 1 | 3.65 | 4.78 | 5.44 | 15.29 | 4.9 | 3.15 |
| 19 | 21.00 | 471 | 472; 473 | Corosolic acid 1 | 0.00 b | 0.00 b | 0.00 b | 0.00 b | 142.74 a | 0.00 b |
| 20 | 25.89 | 455 | 456 | Ursolic acid 1 | 8.95 c | 0.00 c | 0.00 c | 0.00 c | 21.43 b | 150.93 a |
| 21 | 25.95 | 184 | 157 | N4-Acetylsulfadiazine1 | 0.00 c | 0.00 c | 20.57 a | 13.36 b | 0.00 c | 0.00 c |
| DPPH | ABTS | |||||
|---|---|---|---|---|---|---|
| Extract | Media | TD * | Media | TD | ||
| Constanti | 100.13 | ± | 11.14 c | 381.83 | ± | 38.89 a |
| D01-188 | 102.61 | ± | 3.91 c | 323.37 | ± | 34.78 ab |
| Lauranne | 197.97 | ± | 29.69 a | 304.14 | ± | 32.23 abc |
| Marta | 157.70 | ± | 12.57 b | 234.78 | ± | 28.95 c |
| S4017 | 16.31 | ± | 1.33 e | 127.85 | ± | 24.79 d |
| Vairo | 61.10 | ± | 2.62 d | 238.07 | ± | 27.73 bc |
| B. cereus | S. aureus | E. coli | S. choleraesuis | L. innocua | L. monocytogenes | |||||||||||||
|---|---|---|---|---|---|---|---|---|---|---|---|---|---|---|---|---|---|---|
| Mean | TD * | Mean | TD | Mean | TD | Mean | TD | Mean | TD | Mean | TD | |||||||
| Extract (E) | ||||||||||||||||||
| Constanti | 66.83 | ± | 26.57 c | 81.97 | ± | 12.3 b | 73.54 | ± | 11.06 b | 97.11 | ± | 3.85 a | 52.36 | ± | 10.31 c | 53.71 | ± | 25.32 cd |
| D01-188 | 34.88 | ± | 44.99 d | 41.71 | ± | 26.99 d | 54.15 | ± | 16.27 d | 85.90 | ± | 14.11 b | 49.81 | ± | 13.54 c | 42.89 | ± | 32.86 d |
| Lauranne | 77.00 | ± | 35.91 b | 64.83 | ± | 45.69 c | 71.67 | ± | 26.49 bc | 73.83 | ± | 27.01 b | 75.50 | ± | 23.76 b | 73.83 | ± | 42.76 b |
| Marta | 34.00 | ± | 50.37 d | 59.33 | ± | 30.18 c | 66.33 | ± | 17.59 bc | 85.00 | ± | 19.80 b | 67.67 | ± | 24.27 b | 66.17 | ± | 24.36 bc |
| S4017 | 99.37 | ± | 1.13 a | 99.04 | ± | 1.48 a | 98.20 | ± | 3.10 a | 99.00 | ± | 1.75 a | 98.08 | ± | 0.93 a | 94.76 | ± | 4.59 a |
| Vairo | 34.40 | ± | 50.67 d | 85.58 | ± | 20.82 b | 61.98 | ± | 0.85 cd | 89.32 | ± | 5.01 ab | 66.14 | ± | 23.44 b | 50.62 | ± | 37.42 d |
| Concentration (C) (mg·L−1) | ||||||||||||||||||
| 1600 | 97.42 | ± | 3.63 a | 91.49 | ± | 13.07 a | 77.75 | ± | 19.67 a | 95.56 | ± | 5.51 a | 86.18 | ± | 17.27 a | 89.92 | ± | 11.90 a |
| 800 | 47.87 | ± | 45.05 b | 43.19 | ± | 14.72 b | 70.85 | ± | 19.62 a | 91.60 | ± | 8.06 a | 64.36 | ± | 19.71 b | 63.94 | ± | 26.85 b |
| 400 | 27.94 | ± | 37.34 c | 41.99 | ± | 37.55 b | 64.33 | ± | 19.71 b | 77.92 | ± | 23.80 b | 54.24 | ± | 21.86 c | 37.14 | ± | 33.41 c |
| p values | ||||||||||||||||||
| Pe | <0.001 | 0.044 | <0.001 | 0.048 | 0.012 | <0.001 | ||||||||||||
| Pc | <0.001 | 0.038 | <0.001 | 0.036 | 0.032 | 0.050 | ||||||||||||
| Pe*c | <0.001 | 0.047 | <0.001 | 0.025 | 0.062 | 0.009 | ||||||||||||
| M. fructicola | B. cinerea | A. flavus | A. niger | P. expansum | |||||||||||
|---|---|---|---|---|---|---|---|---|---|---|---|---|---|---|---|
| Extract | Mean | TD * | Mean | TD | Mean | TD | Mean | TD | Mean | TD | |||||
| Control | 56.70 | ± | 2.75 | 74.80 | ± | 2.75 ab | 66.30 | ± | 2.80 a | 80.90 | ± | 1.39 a | 61.40 | ± | 1.56 a |
| Constanti | 57.50 | ± | 2.50 | 60.75 | ± | 0.35 c | 52.50 | ± | 0.71 b | 76.33 | ± | 1.15 b | 48.17 | ± | 0.29 b |
| D01-188 | 60.83 | ± | 2.89 | 80.00 | ± | 2.00 ab | 65.50 | ± | 0.71 a | 73.67 | ± | 2.31 b | 49.83 | ± | 1.26 b |
| Lauranne | 66.33 | ± | 2.31 | 60.67 | ± | 8.01 c | 60.83 | ± | 2.89 a | 76.00 | ± | 1.73 b | 51.00 | ± | 7.47 ab |
| Marta | 64.67 | ± | 4.51 | 71.17 | ± | 4.65 ab | 61.00 | ± | 2.60 a | 77.00 | ± | 1.73 b | 61.67 | ± | 6.29 a |
| S4017 | 60.00 | ± | 2.50 | 83.25 | ± | 2.47 a | 61.00 | ± | 1.41 a | 76.00 | ± | 1.00 b | 44.50 | ± | 7.26 b |
| Vairo | 60.83 | ± | 10.41 | 70.17 | ± | 6.81 bc | 54.67 | ± | 0.58 b | 73.50 | ± | 1.32 b | 48.50 | ± | 2.12 b |
Disclaimer/Publisher’s Note: The statements, opinions and data contained in all publications are solely those of the individual author(s) and contributor(s) and not of MDPI and/or the editor(s). MDPI and/or the editor(s) disclaim responsibility for any injury to people or property resulting from any ideas, methods, instructions or products referred to in the content. |
© 2025 by the authors. Licensee MDPI, Basel, Switzerland. This article is an open access article distributed under the terms and conditions of the Creative Commons Attribution (CC BY) license (https://creativecommons.org/licenses/by/4.0/).
Share and Cite
Gizaw, Y.; Benito, M.J.; Gudiño, I.; Caballero, M.d.C.; Córdoba, M.d.G.; Casquete, R. Antioxidant and Antimicrobial Activities of Optimized Extract Obtained from Almond Shell Residues. Molecules 2025, 30, 2614. https://doi.org/10.3390/molecules30122614
Gizaw Y, Benito MJ, Gudiño I, Caballero MdC, Córdoba MdG, Casquete R. Antioxidant and Antimicrobial Activities of Optimized Extract Obtained from Almond Shell Residues. Molecules. 2025; 30(12):2614. https://doi.org/10.3390/molecules30122614
Chicago/Turabian StyleGizaw, Yesuneh, María José Benito, Iris Gudiño, María del Carmen Caballero, María de Guía Córdoba, and Rocío Casquete. 2025. "Antioxidant and Antimicrobial Activities of Optimized Extract Obtained from Almond Shell Residues" Molecules 30, no. 12: 2614. https://doi.org/10.3390/molecules30122614
APA StyleGizaw, Y., Benito, M. J., Gudiño, I., Caballero, M. d. C., Córdoba, M. d. G., & Casquete, R. (2025). Antioxidant and Antimicrobial Activities of Optimized Extract Obtained from Almond Shell Residues. Molecules, 30(12), 2614. https://doi.org/10.3390/molecules30122614

